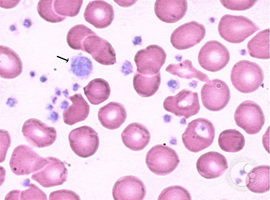
Synergistic Effect of Pegylated Interferon and Ruxolitinib in the Treatment of Resistant Essential Thrombocytosis

Oskar Lepiarczyk and Aaron Niblock*
Consultant Haematologist, Antrim Area Hospital, United Kingdom
*Corresponding author: Aaron Niblock, Consultant Haematologist, Antrim Area Hospital, United Kingdom. E-mail: aaronniblock@doctors.net.uk
Received: May 25, 2022; Accepted: June 11, 2022; Published: June 28, 2022
Citation: Lepiarczyk O, Niblock A. Synergistic Effect of Pegylated Interferon and Ruxolitinib in the Treatment of Resistant Essential Thrombocytosis. Clin Image Case Rep J. 2022; 4(6): 243.